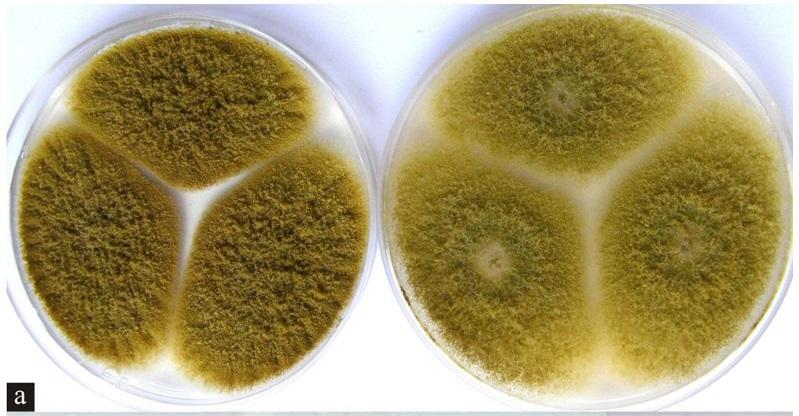

¿Qué es el agar Czapek?
El agar Czapek (CZA) es un medio de cultivo sólido selectivo, especialmente diseñado para el cultivo de bacterias y hongos saprófitos. Fue creado por el botánico polaco Friedrich Johann Franz Czapek y el químico estadounidense Arthur Wayland Dox; por ello a este agar también se le conoce como medio Czapek-Dox.
El medio original era líquido, pero posteriormente se le agregó agar para hacerlo sólido. El medio Czapek está compuesto por nitrato de sodio, fosfato bipotásico, sulfato de magnesio, cloruro de potasio, sulfato ferroso, sacarosa, agar y agua destilada.
El pH del agar Czapek es de 7.3, pero existe una variante a la que se le adiciona ácido láctico al 10%, cuyo pH queda en 3,5. Este medio ácido se utiliza para el cultivo de microorganismos acidófilos.
Por otra parte, algunas casas comerciales modificaron la composición del agar Czapek cambiando el sulfato de magnesio y el fosfato bipotásico por glicerofosfato. Esta modificación evita que se forme el precipitado de fosfato de magnesio observado con la fórmula convencional. Asimismo, existe otra variante a la cual se le adiciona extracto de levadura.
Finalmente, el agar Czapek es recomendado por la Asociación Americana de Salud Pública APHA para el estudio de Actinomycetes sp., Aspergillus sp., Paecilomyces sp. y Penicillium sp. Estas especies se caracterizan por ser microorganismos ambientales y patógenos oportunistas.
Fundamento
Este medio contiene sacarosa, que sirve como fuente de carbono, en tanto que el nitrato de sodio es la fuente de nitrógeno, pero a diferencia de otros medios, el nitrógeno proporcionado es de tipo inorgánico.
Por este motivo, el medio Czapek se considera selectivo, debido a que solo podrán desarrollarse microorganismos capaces de utilizar compuestos inorgánicos como única fuente de nitrógeno.
Como sustancia reguladora de la osmolaridad del medio está el fosfato bipotásico. Por su parte, el sulfato de magnesio, el cloruro de potasio y el sulfato ferroso aportan minerales esenciales para el crecimiento de los microorganismos saprófitos (de vida libre). Con esta fórmula se forma un precipitado de fosfato de magnesio.
Finalmente, el agar-agar es el compuesto que le proporciona la consistencia sólida al medio y el agua es el disolvente de todos los componentes.
Con la fórmula del agar Czapek modificado no hay formación de precipitado y mejora el rendimiento en el crecimiento de algunos hongos.
La acidez extrema del agar Czapek ácido hace que este sea un medio más selectivo, permitiendo solo el crecimiento de microorganismos acidófilos, capaces de utilizar el nitrógeno inorgánico. En tanto que el agar Czapek-levadura mejora el rendimiento de ciertos hongos.
Preparación
Medio Czapek-Dox
- Pesar 49 gr del medio de cultivo deshidratado y disolver en agua destilada.
- Aplicar calor hasta hervir.
- Agitar la mezcla frecuentemente hasta disolver completamente.
Cuñas de agar Czapek
- Distribuir la mezcla disuelta en tubos y autoclavar a 121 °C por 15 minutos.
- Al sacar del autoclave, homogeneizar antes de acostar los tubos y dejar solidificar.
Placas de agar Czapek
- Autoclavar la mezcla disuelta a 121 °C por 15 minutos y al salir dejar enfriar a 50 °C, homogeneizar y verter 20 ml en placas de Petri estériles.
- Dejar solidificar, invertir y guardar en nevera hasta su uso. El pH debe quedar en 7,3 ± 0,2. El color del medio deshidratado es blanco y preparado es ámbar claro, ligeramente turbio por la presencia de un precipitado floculante.
Medio Czapek a pH ácido
- Preparar como ya fue descrito, pero adicionando 10 ml de ácido láctico estéril al 10% por cada litro de medio preparado. El medio Czapek modificado debe quedar a pH 3,5 ± 0,2.
Medio Czapek modificado
- Pesar 45,4 gr del medio deshidratado y disolver en 1 litro de agua.
- El resto de la preparación es igual a la descrita anteriormente. El color del medio deshidratado es blanco, y preparado es de color blanquecino. El pH final del medio es de 6,8 ± 0,2.
Medio Czapek-levadura
- También llamado agar Czapek-extracto de levadura (CYA). Contiene los elementos del agar Czapek clásico más extracto de levadura.
Usos
- El medio Czapek se usa para buscar microorganismos saprófitos en muestras de suelo, vegetales, granos, aire, insectos, entre otros.
- El agar Czapek a pH ácido se usa para el crecimiento de microorganismos acidófilos.
- El agar Czapek modificado es especialmente útil para la formación de clamidosporas en especies del complejo Candida albicans.
- El agar Czapek-levadura es muy útil para el aislamiento de Aspergillus y Penicillium.
Sembrado
Agar Czapek
- Para buscar Actinomicetos en el suelo se procede de la siguiente manera: se trata la muestra con agua fenolizada por 30 min y posteriormente se siembra 1 mL de la suspensión en el agar Czapek. Se incuba a 28 °C por 5 a 7 días.
- Para muestras de vegetales, granos e insectos se colocan directamente sobre el agar. También se pueden hacer diluciones y sembrar 0,1 ml sobre la superficie del agar.
Agar Czapek modificado
- Para el sembrado se utiliza un asa recta o aguja, se impregna con el hisopo y se inocula el agar haciendo una punción hasta tocar la base de la placa.
- Incubar por 24 horas a 28 °C y examinar con un microscopio por encima y por debajo de la placa para observar si se han formado las clamidosporas.
Temperatura y tiempo de incubación
- La temperatura y el tiempo de incubación varían dependiendo del tipo de microorganismo que se busca aislar. Por lo general, las placas se incuban por una a dos semanas en un rango de temperatura de 20 a 25 °C.
- Existen condiciones específicas para algunas cepas. Por ejemplo, la mayoría de las especies del género Aspergillus tienen un crecimiento óptimo a 30 °C. Sin embargo, A. fumigatus crece a 50 °C.
- En cuanto al tiempo de incubación, una o dos semanas es lo normal, sin embargo, Candida albicans puede desarrollarse en 24 a 48 horas a 25 °C.
Características de algunas colonias en este medio
Penicillium atrovenetum
- Se desarrolla en 12 días de incubación a 27 °C. Sus colonias son pequeñas (25 mm).
- Las colonias tienen aspecto aterciopelado, con borde definido color blanco y en el centro presenta una tonalidad azul verdosa que conforme envejece se vuelve gris. El reverso de la colonia es anaranjado, colocando al medio del mismo color por la producción de pigmento.
Aspergillus niger
- Se desarrolla con un micelio de color blanco a amarillo y esporas de color negro.
Candida albicans
- Se desarrollan colonias cremosas de color beige claro. En el agar Czapek modificado forma clamidosporas.
Aspergillus parasiticus
- Se desarrolla un micelio de color verde oscuro en 7 días a 25 °C.
Control de calidad
Para evaluar la calidad del medio de cultivo se pueden sembrar cepas control certificadas, tales como: Aspergillus niger, MKTA 16404, Candida albicans, MKTA 10231.
Aspergillus niger desarrolla un micelio de color blanco a amarillo y esporas de color negro en 5 días aproximadamente, mientras que Candida albicans tendrá un crecimiento satisfactorio en 24 horas de incubación a 25 °C. Las colonias son color crema.
Limitaciones
Algunos estudios han revelado que para la recuperación de Actinomicetos, el agar con mejor rendimiento es el agar papa dextrosa, quedando el agar Czapek en segundo lugar, pero para la recuperación de Aspergillus y Penicillium, el agar Czapek es el que brinda la mayor tasa de recuperación.
Referencias
- Dávila, M, et al. Actinomicetos antagónicos contra hongos fitopatógenos de importancia agrícola. Recuperado de scielo.org.
- Luna, M., Lozada, Y., Trigos, Á. Aislamiento de cepas de Aspergillus niger, productoras de ocratoxina A, en café verde (Coffea arábica) almacenado. Recuperado de scielo.org.
- Czapek medium. Recuperado de en.wikipedia.org.
- Agar Czapek-Dox Modificado. Recuperado de condalab.com.
- Czapek-Dox Agar. Recuperado de medioscultivo.com.